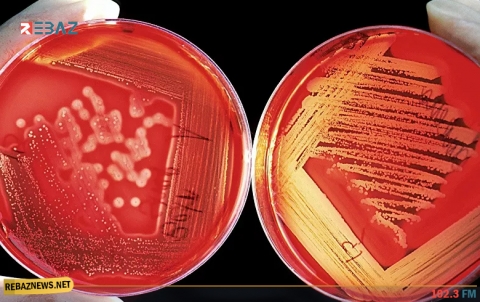
أعراض تستدعي استشارة طبيب الأورام بشكل عاجل

فقدان الوزن
تؤدي درجات الحرارة المنخفضة في فصل الشتاء والبحث عن الشعور بالدفء إلى الشعور الزائد بالجوع، مما يجعل الشخص يتناول كميات...
يحتوي الأفوكادو على الكثير من العناصر الغذائية التي تساهم في بناء جسم الإنسان وزيادة قدرته على آداء الوظائف الحيوية ومكافحة...
دحض العلماء الأسطورة الشائعة القائلة بأن تناول معظم السعرات الحرارية في الصباح يؤثر على فقدان الوزن، وفقًا لتقارير نقلت بيانات...
تعتبر الأطعمة عالية البروتين ومنخفضة السعرات الحرارية خيارًا رائعًا إذا كنت تحاول إنقاص وزنك والحفاظ على الشكل المثالى الخالى من...
يمثل تراكم الدهون في منطقة البطن وظهور الكرش، مشكلة تزعج الكثيرين سواء من الرجال أو النساء. ولمواجهة هذه المشكلة من...
كشف خبير تغذية عن أهم الفوائد الصحية لتناول الشاي الأخضر، والتي على رأسها التخلص من الوزن الزائد. وقال الدكتور شريف...
لكن هناك مجموعة من الأشياء البسيطة والسهلة التي يمكن للشخص القيام بها لزيادة التمثيل الغذائي لديه وجعل جسمه يعمل بشكل...
تحدث كبير أطباء الأورام في وزارة الصحة الروسية أندريه كابرين عن الأعراض التي تتطلب عناية طبية عاجلة. وفقًا للاختصاصي، يمكن...